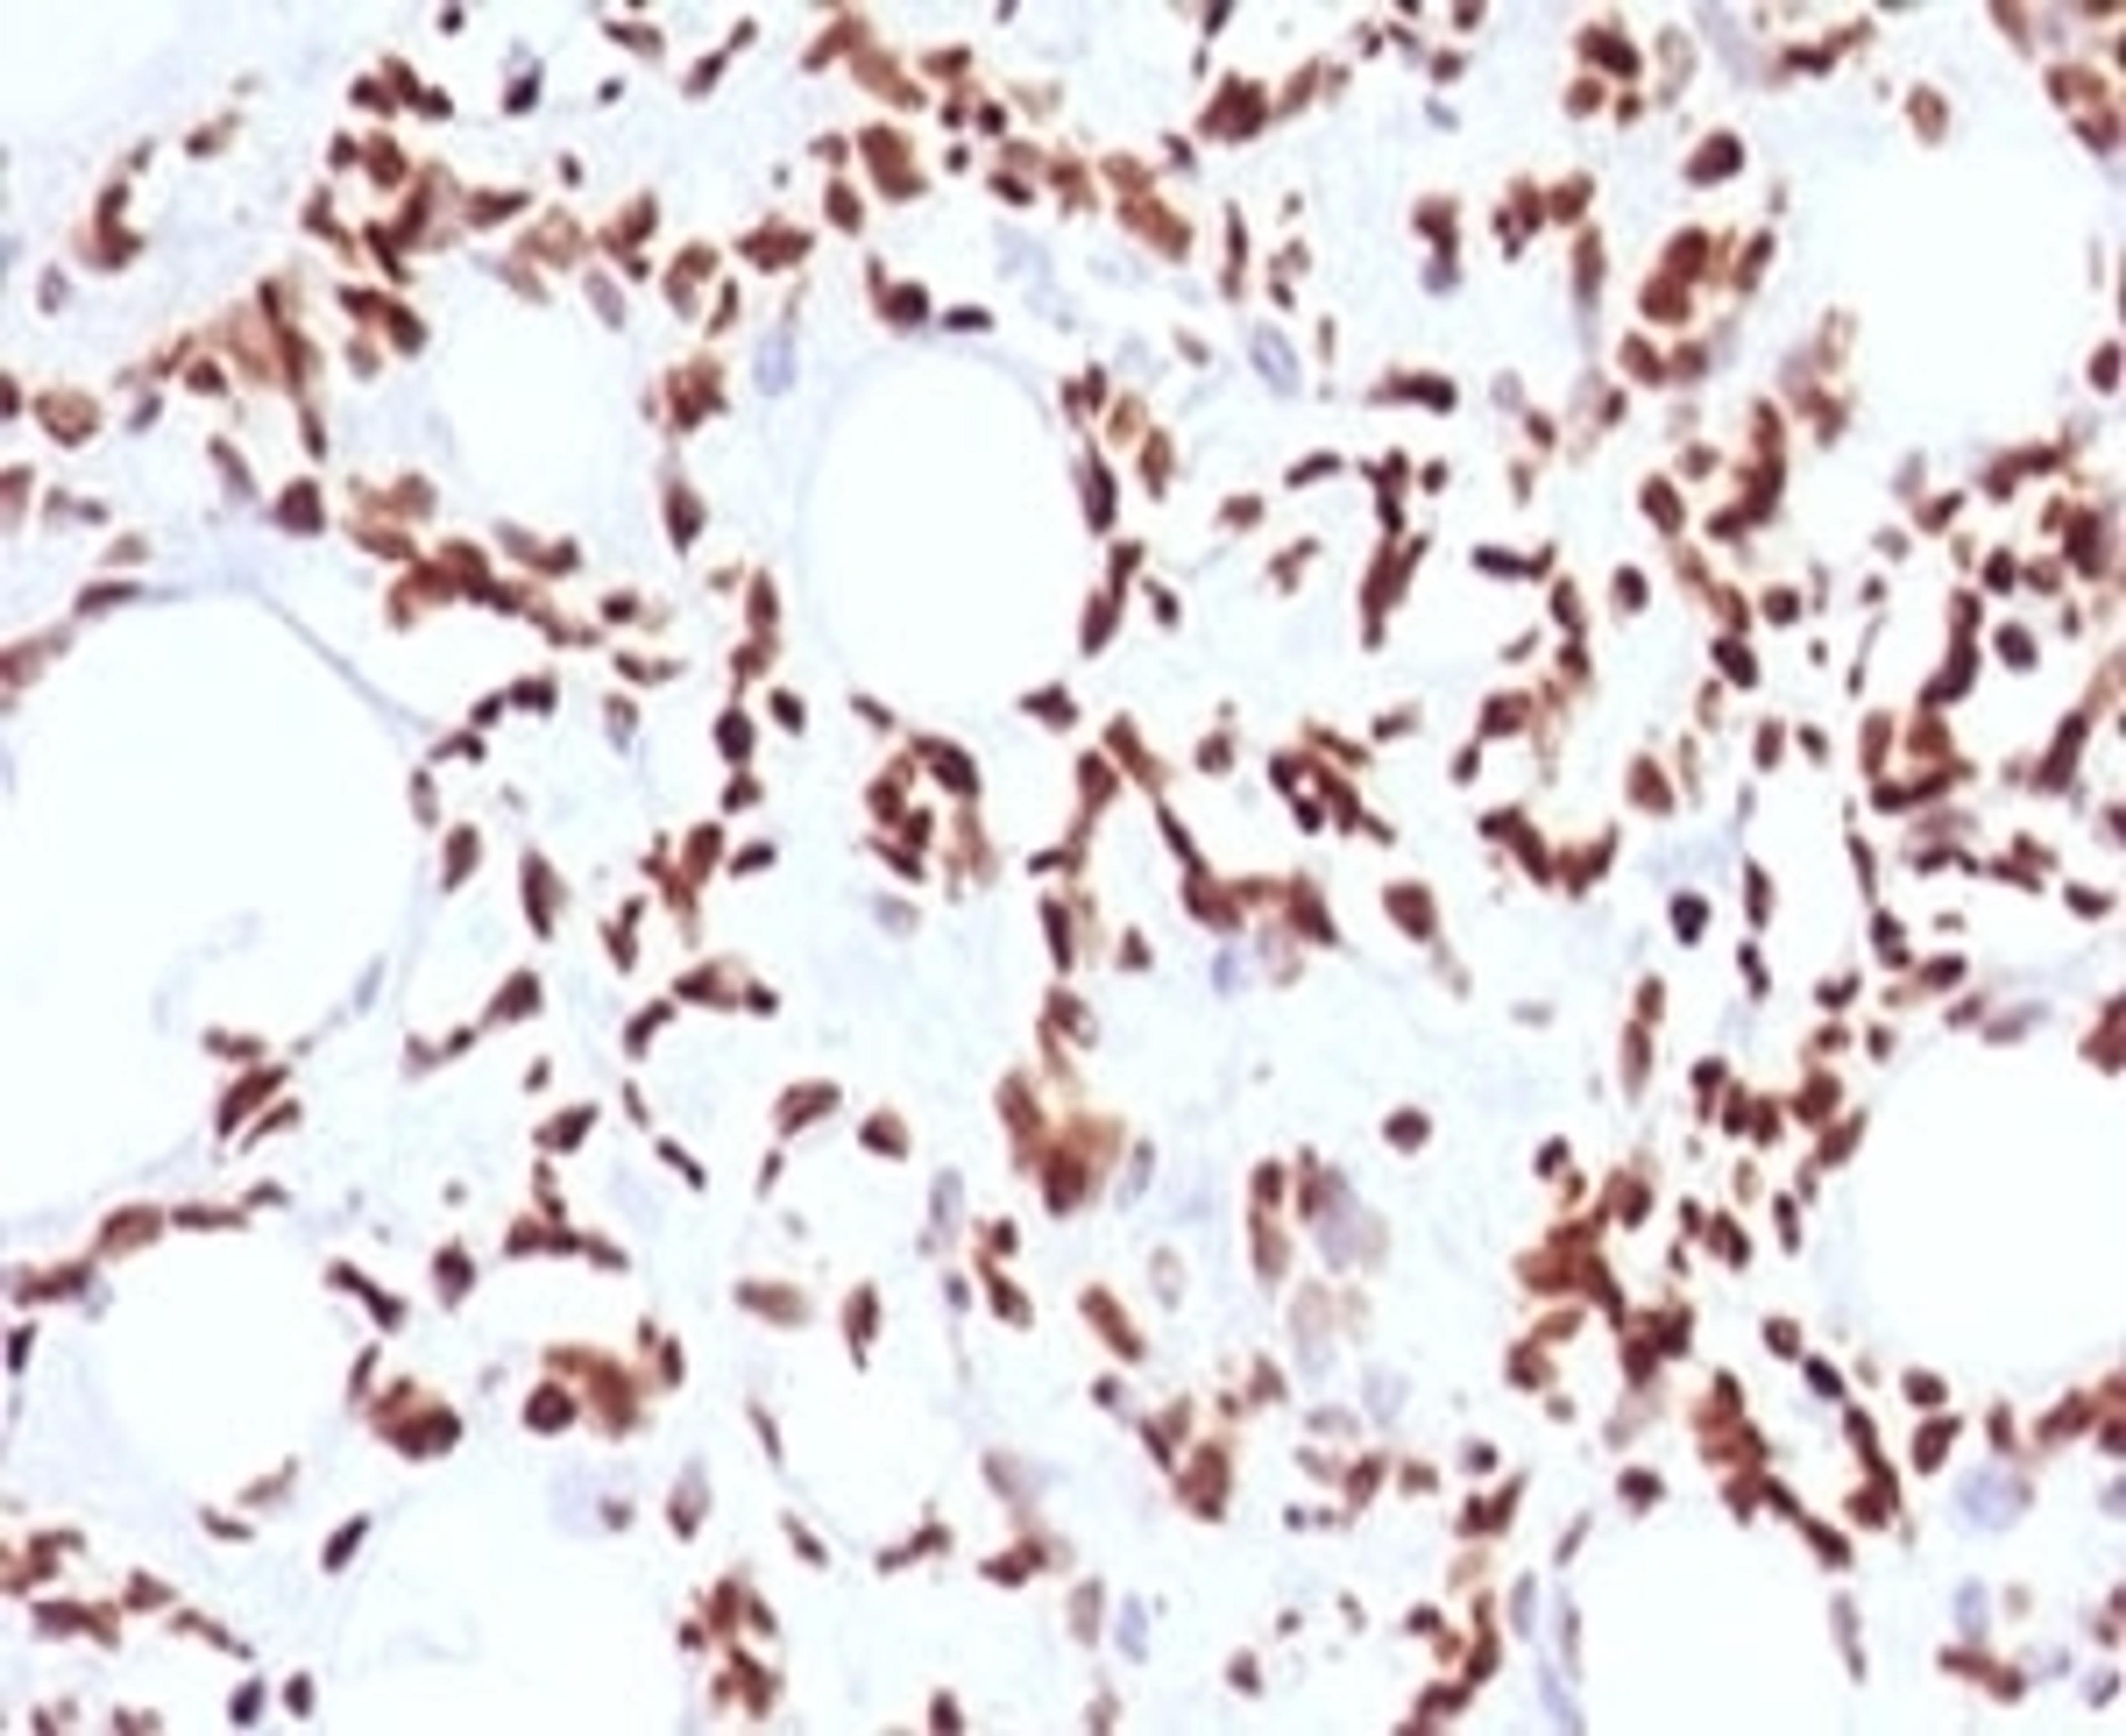

Product & ReviewsAntibodies
Histone H1 Antibody [OSHT-2]
Product Details
- Cat. No.
- 33-975
- Type
- Primary Antibody
- Clonality
- Monoclonal
- Host
- Mouse

The supplier does not provide quotations for this antibody through SelectScience. You can search for similar antibodies in our Antibody Directory.
Description
Histone H1 Antibody [OSHT-2] raised in Mouse validated in Flow, IF, IHC-P in Human, Mouse, Rat.
Biological Information
- Clonality: Monoclonal
- Host: Mouse
- Conjugate: Unconjugated
Handling
- Quantity: 100 ug
- Storage: Aliquot and Store at 2-8˚C. Avoid freez-thaw cycles.
- Buffer: PBS with 0.1 mg/ml BSA and 0.05% sodium azide